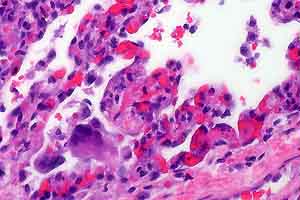
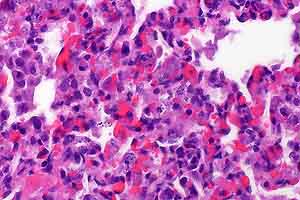

Results
AFIP Wednesday Slide Conference - No. 28
10 May 2000
- Conference Moderator:
Dr. Daniela Ennulate, Diplomate, ACVP
Schering-Plough Research Institute
PO Box 32, 144 Route 94
Lafayette, NJ 07848-0032
- Return to WSC Case Menu
-
- Case I - 3030/96 (AFIP 2694912)
-
- Signalment: 2.5-year-old, female, Norwegian horse.
-
- History: The horse had a history of diarrhea for longer
than one week. The feces contained large numbers of small red
nematodes up to 1cm in length. The animal showed reduced appetite,
severe emaciation and a secondary hyperlipidemia. Therefore
clinically a verminous colitis was diagnosed.
Over three days the horse was treated with electrolyte infusion,
peristaltic and antiphlogistic agents, but the general condition
remained bad, so the horse was euthanized, because of poor prognosis.
-

- Case 28-1. Colon. Mucosal folds are swollen (edema).
Abundant reddish-brown foci represent embedded nematode (Cyathostome)
larvae.
-
- Gross Pathology: The horse was partly necropsied by
the veterinary surgeon and only parts of the large bowel were
submitted for further microscopical examination. The gut wall
of the large intestine was thickened due to a submucosal edema.
On the luminal surface numerous submucosal and mucosal nodules,
ranging from 6 mm in diameter to dark, tiny punctate lesions,
could be detected.
-
- Laboratory Results: PCV: 39.4%; pH of the blood: 7.24;
BE: 13 mmol/l (metabolic acidosis).
-
- Contributor's Diagnoses and Comments:
- 1. Colon: subacute multifocal moderate to severe granulomatous
colitis with sections of nematode larvae in the lamina propria
mucosa and tela submucosa.
2. Moderate submucosal edema.
Etiology: Larval cyathostomiasis
-
- According to the stage of inflammation, focal or diffuse
mucosal infiltrations with macrophages and neutrophils or parasitic
granulomas dominate the lesions. The amount of eosinophils varied
within the affected areas. In the submitted slides no eosinophils
could be detected. The mucosal nodules consisted of larvae residing
in dilated glandular crypts of mucosal cysts. The submucosal
nodules contained parasites with a fibrous capsule surrounded
by an intense inflammatory reaction, composed largely of macrophages
and epithelioid cells, with fewer lymphocytes, plasma cells and
neutrophils. As a residue of emigrated larval nematodes there
was a focal accumulation of mononuclear cells in the mucosa.
The intense mucosal edema was confirmed histologically. In
addition some focal lymphangiectasia and medial hyperplasia of
a few arteries accompanied the inflammatory reaction. In some
sections, nematodes were found in lymph nodes, which could be
interpreted as an incidental finding of aberrant larvae.
-
- The most important helminthoses of horses are caused by nematodes,
mainly by large strongyles (especially Strongylus vulgaris).
Additionally members of the small strongyles are common nematode
parasites of the colon and cecum in horses, usually present in
mixed infestation (see slide). "Larval cyathostomiasis"
has become more important recently due to the resistance of small
strongyles against benzimidazoles.
-
- The subfamily Cyathostominae, or small strongyles, includes
eight genera of nematodes. Mainly the larvae have pathogenic
significance. The larval stages (L3) migrate into the deep mucosa
or submucosa of the large bowel (mainly cecum and ventral colon)
from the gut lumen and enter the glands of Lieberkühn to
molt and develop, before emerging into the lumen to molt again
and mature. Larvae developing within cysts in the mucosal layer
may alter these glands, with localized hypertrophy and hyperplasia
of goblet cells. Local eosinophilia, edema and rupture of the
muscularis mucosa are caused by the emergence of larvae, followed
by infiltration of neutrophils and macrophages. Third or fourth-stage
larvae may undergo hypobiosis or retarded development, only to
mature sporadically as the adult population in the lumen turns
over or is lost.
-
- The disease "larval cyathostomiasis" is caused
by maturation of large numbers of larvae leading to a leakage
of the mucosal barrier. Only horses older than one year become
ill and develop diarrhea, ill thrift or cachexia and hypoalbuminemia.
However, these animals very often lack signs of eosinophilia.
The mucosa is congested and edematous. If the mucosal damage
is severe, there may be a fibrinous exudate on the eroded or
ulcerated surface.
-
 4x
4x 2x
2x
- Case 28-1. Colon. Multifocally expanding the mucosa,
submucosa, and lamina propria there are multiple sections of
nematode larvae representing several stages of development.
-
- AFIP Diagnosis: Colon: Colitis, lymphoplasmacytic
and granulomatous, chronic, multifocal, severe, with edema and
mucosal and submucosal strongyle larvae, Norwegian horse, equine.
-
- Conference Note: This case was reviewed by Chris H.
Gardiner, PhD, our parasitology consultant. He agreed that the
parasites are true strongyles, but was unable to further classify
them.
-
- In many areas, cyathostomes are now the main parasitic pathogen
of the horse. This rise in prominence is a result of the marked
decrease in prevalence of large strongyles caused by widespread
use of modern anthelmintic compounds. Clinically normal horses
can harbor tens of thousands of cyathostomes without apparent
disease. Cyathostomes are pathogenic at times of both penetration
and emergence from the large intestinal mucosa. Clinical disease
occurs most often in young horses in the late winter and early
spring when large numbers of larvae mature synchronously.
-
- Contributor: Institut für Veterinär-Pathologie,
Justus-Liebig-Universität Giessen; Germany.
-
- References:
- 1. Barker IK, Van Dreumel, Palmer N: The Alimentary System.
In: Pathology of Domestic Animals, eds. Jubb KVF, Kennedy
PC, Palmer N, vol. 2, 4th ed, pp. 281-283. Academic press, San
Diego, Ca, 1993
- 2. Giles CJ, Urquhart KA, Longstaffe JA: Larval cyathostomiasis
(immature Trichonema-induced enteropathy): A report of 15 clinical
cases. Equi Vet J 17:196-201, 1985
- 3. Reinemeyer CR, Powell HS: Larval Cyathostomiasis in three
horses in Tennessee. Amer Ass Vet Lab Diag 29:69-76, 1986
- 4. Reinemeier CR: Small Strongyles; recent advances. Vet
Clin North Am 2:281-311, 1986
- 5. Schillinger D, Hasslinger MA: Benzimidazole resistance
in small strongyles of horses - Occurrence in Germany and strategies
for avoiding resistance. Revue Med Vet 145:119-124, 1994
- 6. Love S, Murphy D, Mellor D: Pathogenicity of cyathostome
infection. Vet Parasitol 85:113-121, 1999
-
-
- Case II - S99-1215 (AFIP 2686534)
-
- Signalment: 22-day-old male quarter horse foal.
-
- History: The foal showed signs of neonatal maladjustment
syndrome and was in lateral recumbency with opisthotonus. He
appeared to have cervical muscular pain and would seldom elevate
his head. He was treated intensely, but remained weak and would
drink milk from a pan but not nurse. He was outside grazing
at the time of agonal collapse. The mare has had three foals,
another of which died at birth.
-
- Gross Pathology: There was evidence of normal recent
feeding and some firm fecal balls in the colon. There was no
body fat and marked serous atrophy, especially obvious in the
coronary grooves. The ductus arteriosus was patent (>10mm).
Left and right ventricular endocardium was opaque white and
distinctly thickened to 2-3mm. Myocardium and skeletal muscle
appeared grossly normal, as did all other organ systems.
-
- Laboratory Results: Reported were persistent neutropenia,
low thyroid values, and persistently elevated CK and AST values.
No bacterial growth from CSF. Liver selenium 0.301 ppm wet
wt, judged within normal limits, as were other heavy metal screen
values.
-
- Contributor's Diagnoses and Comments:
- 1. Skeletal and myocardial degeneration with intra- and extra-cellular
basophilic bodies
2. Endocardial fibroelastosis
- Cause - Metabolic myopathy
-
- Although there is mild multifocal myocyte degeneration and
necrosis, the predominate change is the presence of variably
large, waxy, bluish, amorphous bodies, extracellular and in the
sarcoplasm, especially striking in the Purkinje conduction system.
These bodies are sometimes vaguely laminated and prove PAS-positive,
diastase-resistant and are also prominent in the brain, where
they are visible with H&E. They are iodine-positive and
Congo red-negative. A few are identified in nerves within the
muscle fascicles and they are present in splenic macrophages
and hepatic Kupffer cells.
-
- The specific biochemical abnormality remains to be identified
at this time but this appears to be a deficiency of a glycogen
branching enzyme leading to inherited hypoglycemia, sepsis, cardiomyopathy
and rhabdomyolysis in neonatal quarter horses. The fibroelastosis
(proven with elastic stains) and PDA have apparently not been
reported as parts of this syndrome.
-
- Another recent report characterizing amylopectinosis in quarter
horses shows many similarities, but not the crystals nor staining
in the tongue in this present foal. That report suggested a
form of glycogen storage disease, Type IV.
-
 20x
20x
- Case 28-2. Multifocally myocardial muscle fibers are
expanded by variably sized, round, basophilic inclusions.
-
- AFIP Diagnoses:
- 1. Heart, cardiomyocytes and Purkinje fibers: Amphophilic
to basophilic intrasarcoplasmic inclusions, diffuse, numerous,
quarter horse, equine.
2. Heart: Endocardial fibroelastosis, diffuse, moderate.
3. Skeletal muscle: Degeneration and necrosis, individual myofibers,
multifocal, few, with scattered amphophilic to basophilic intrasarcoplasmic
inclusions.
-
- Conference Note: Two similar conditions in the horse
have been recently reported, amylopectinosis (Render JA et al.)
and equine polysaccharide storage myopathy (EPSSM) (Valentine
BA et al.). There is abnormal accumulation of polysaccharides
in both conditions, characterized by cytoplasmic inclusions that
are PAS positive, diastase resistant and Congo red negative.
-
- Amylopectinosis is described only in neonatal quarter horses.
Amylopectin is similar to glycogen, but differs by having fewer
a 1, 6 linked branch points and longer unbranched a 1, 4-linked
chain segments. Although studies have not yet identified a specific
defect in glycolytic or glycogenolytic pathways, the similarities
to human type IV glycogen storage disease (caused by a deficiency
of glycogen branching enzyme) cannot be denied. In amylopectinosis,
cytoplasmic inclusions stain blue to black when treated with
iodine, indicating a large amount of long unbranched chains.
Inclusions are found in multiple tissues, including skeletal
muscle (especially the tongue), cardiomyocytes, nerves, brain
and spinal cord. Amylopectin must be differentiated from corpora
amylacea and Lafora bodies, which have similar staining characteristics.
-
- In contrast, EPSSM has been described in various horse and
pony breeds and is characterized by repeated bouts of exertional
rhabdomyolysis and generalized muscle atrophy in animals 8 months
of age and older. Cytoplasmic inclusions are PAS positive, amylase
resistant, and are found in skeletal muscle only.
-
- Contributor: California Veterinary Diagnostic Laboratory-
San Bernardino, 105 W Central Avenue, Box 5579, San Bernardino,
CA 92412.
-
- References:
- 1. Render JA, Common RS, Kennedy FA, Jones MZ, Fyfe JC:
Amylopectinosis in Fetal and Neonatal Quarter Horses. Vet Pathol
36:157-160, 1999
- 2. Valberg SJ, Hiraragi H, Ward TL, Rush B, Kinde H, Mickelson
JR: Glycogen branching enzyme deficiency: an emerging cause of
neonatal mortality in foals (abstract). J Vet Internal Med 12:234,
1998
- 3. Valentine BA, McDonough PP, Chang YF, Vonderchek: Polysaccharide
storage myopathy in Morgan, Arabian, and Standardbred related
horses and Welsh-cross ponies. Vet Pathol 37:193-196, 2000
-
-
- Case III - TAMU 97-1 (AFIP 2594829)
-
- Signalment: 14-year-old, thoroughbred, female, equine
-
- History: The mare had a two-month history of tail
rubbing and loss of hair around the tail head. There was a progressive
atrophy of the muscles of the rump and mild ataxia. The skin
around the tail had lost sensation and the mare was fecal incontinent.
-
- Gross Pathology: The mare was euthanized, and at necropsy,
the rectum was distended to 25 cm diameter. The urinary bladder
was full of urine and turbid, gritty sediment. The spinal cord
from the last lumbar nerves caudally was surrounded by brown-red
fibrous tissue that coated the nerves of the cauda equina.
-
- Contributor's Diagnosis and Comments: Chronic, extradural,
fibrosing, granulomatous neuritis and perineuritis, Büngner
band formation, demyelinating, neuropathy (neuritis of the cauda
equina).
-
- The sections submitted tried to demonstrate that the reaction
is extra dural, and at the level of the section, it is asymmetric
in involvement of the extradural nerve roots. Although there
is a mild microgliosis with an occasional degenerated axonal
fiber, the spinal cord is minimally affected; however, the perineurium
is thickened by fibrous connective tissue and an infiltration
by lymphocytes, macrophages, plasma cells and neutrophils with
a rare multinucleated macrophage. The circumferential wraps
of sheath cells (Büngner's bands) are impressive. Nerves
are compressed and demyelinated. Less-affected nerves have cuffed
vessels.
-
- The gross and histologic observations in this case of neuritis
of the cauda equina are typical of published cases. The presenting
complaints indicated disease in the lumbar and sacral areas and
the gross lesions reflected that. There was a ganglioneuritis
of the trigeminal and cervical ganglia, but no other lesions
were noted in the CNS. The fibrous tissue surrounding the cauda
equina prevented separation of nerves; yet, the reaction stopped
at the dura. This condition affects adult horses of many breeds.
Because antibodies to P2 myelin have been commonly reported
to be present in these animals, this disease is thought to represent
an allergic neuritis similar to human Guillain-Barré syndrome.
A test for P2 antibodies was not run in this horse. The etiology
of this condition is not known. Equine adenovirus was isolated
(after multiple passages) from two, reported cases of equine
cauda equina neuritis.
-
 40x
40x
- Case 28-3. The outlines of degenerate nerve sheaths
are surrounded by an infiltrate of lymphocytes, plasma cells,
rare foreign body giant cells supported by fibrous connective
tissue.
-
- AFIP Diagnosis: Spinal cord, nerve roots: Polyradiculoneuritis,
lymphoplasmacytic, histiocytic, fibrosing, multifocal, mild to
severe, thoroughbred, equine.
-
- Conference Note: Neuritis of the cauda equina has
often been compared to Guillain-Barré syndrome and experimental
allergic neuritis. Similarities include demyelinating changes
in the proximal roots associated with infiltrating mononuclear
cells and macrophages that strip away segments of the myelin
sheaths. It is unclear whether circulating antibodies against
P2 myelin protein represent the cause of the disease or a consequence
of antigen release during myelin destruction. The chronic, unremitting
course, intense granulomatous inflammation of the extradural
roots and prevalence of axonal degeneration in neuritis of the
cauda equina also differ from the previously mentioned immune-mediated
diseases.
-
- Contributor: College of Vet Medicine, Texas A&M
University, College Station, TX 77843-4467.
-
- References:
- 1. Edington N, Wright JA, Patel JR, Edwards GB, Griffiths
L: Equine adenovirus 1 isolated from cauda equina neuritis. Res
Vet Sci 37:252-254, 1984
- 2. Fordyce PS, Edington N, Bridges GC, Wright AJ, Edwards
GB: Use of an ELISA in the differential diagnosis of cauda equina
neuritis and other equine neuropathies. Eq Vet J 19:55-59, 1987
- 3. Kadlubowski M, Ingram PL: Circulating antibodies to the
neuritogenic myelin protein, P2, in neuritis of the cauda equina
of the horse. Nature 293:299-300, 1981
- 4. Summers BA, Cummings JF, de Lahunta A: Veterinary Neuropathology,
pp. 432-434. Mosby-Year Book, Inc., Baltimore, MD, 1995
- 5. Wright JA, Fordyce P, Edington N: Neuritis of the cauda
equina in the horse. J Comp Pathol 97:667-675, 1987
-
-
- Case IV - UCD2 (AFIP 2714532)
-
- Signalment: One-month-old, male, thoroughbred foal
-
- History: This foal was born three weeks prematurely
and had a history of dyspnea with ataxia, aspiration pneumonia
and labored breathing. The foal presented to the Veterinary
Medical Teaching Hospital, bright, alert and responsive but icteric.
Twenty-four hours after presentation the PCV dropped from 22
to 10. Occult blood was present in the feces and the foal was
weakly Coombs' positive. The animal was given a transfusion
with washed red blood cells from the mare. The foal was hypoxic
and was given nasal oxygen. Blood glucose ranged from 50 to
60 despite a continuing good appetite. Radiographs revealed
hypoplastic cuboidal bones in the tarsus and carpus. The foal
was treated with ampicillin, amikacin®, Ranitidine®,
Sucralfate®, Banamine®, dexamethasone, vitamin E, fluid
and dextrose.
-
- Gross Pathology: The animal was icteric. Petechiation
was present on the tongue, gingiva and esophageal mucosa. Both
lungs were diffusely wet, heavy and firm on palpation. On incision
they were moderately to markedly wet. The spleen was approximately
2-3 times normal size and was firm. There were multiple renal
infarcts.
-
- Laboratory Results: WBC: 85,000 one week prior to
presentation. Dropped to 4200 forty-eight hours after hospitalization.
Post mortem cultures of the lungs and liver revealed large numbers
of Candida lusitaniae-like organisms
-
- Contributor's Diagnosis and Comments: Lung: Severe
diffuse subacute interstitial pneumonia with intralesional yeasts
(Candida lusitaniae).
-
- Organisms were also found in the thymus, spleen, and liver.
Additionally there was evidence of erythrophagocytosis in the
spleen as well as disseminated intravascular coagulopathy. Systemic
yeast infections have been observed in neonatal foals, especially
those with complex medical problems or prematurity. Factors
that increase the risk of systemic candidiasis include intravenous
catheters, urinary catheters, endotracheal tubes, and multiple
antibiotic therapy. Systemic Candida infections are also problematic
in premature or ill human infants. Infections can either begin
with colonization of endotracheal tubes or be a result of ascending
infection from the lower genital tract of the mother. In one
study, progression of local, tracheal colonization by Candida
to systemic infection was most frequent in very low birth weight
infants. In humans ascending intra-amniotic infections by a
variety of organisms, including Candida, are major causes of
preterm labor and premature rupture of the membranes. Theoretically
this foal could have become infected by such a route; however,
culture of the mare revealed no Candida species and thus it is
most likely that this foal became infected as a result of debilitation.
-
 40x
40x 40x
40x
- Case 28-4. Occasional foreign body giant cells, macrophages
and cell debris within alveoli and alveolar septa. Scattered
macrophages contain multiple 3-4um basophilic organisms.
-
- AFIP Diagnoses:
- 1. Lung: Pneumonia, interstitial, granulomatous, diffuse,
severe, with numerous intrahistiocytic yeasts, thoroughbred,
equine.
2. Lung, blood vessels: Fibrin thrombi, with yeasts.
-
- Conference Note: Conference participants considered
a broad differential diagnosis that included Histoplasma capsulatum,
Cryptococcus neoformans, Blastomycetes dermatitidis, Sporothrix
schenckii, Coccidioides immitis, Leishmania sp., Toxoplasma gondii,
and Neospora caninum. Candida spp. can be identified in tissue
when yeasts, hyphae and pseudohyphae are all present. In cases
where all three structures are not present, culture is required
for definitive diagnosis. Yeasts, hyphae and pseudohyphae are
clearly evident in sections stained with GMS and PAS.
-
- Along with pneumonia, systemic candidiasis may cause synovitis,
panophthalmitis, meningitis, glossitis, osteomyelitis and cystitis.
-
- Contributor: The University of California, Davis VM-PMI,
1 Shields, Davis, California, 95616.
-
- References:
- 1. Mazor M, Chiam W, Shinwell ES, Glezerman M: Asymptomatic
amniotic fluid invasion with Candida albicans in preterm premature
rupture of membranes: Implications for obstetric and neonatal
management. Acta Obstetrica et Gyneco Scandin 72(1):52-54, 1993
- 2. Reilly L, Palmer JE: Systemic candidiasis in four foals.
J of the Amer Vet Med Assoc 205(3):464-466, 1994
- 3. Rowen JL, Rench M, Kozinetz C, Adams J, Baker C: Endotracheal
colonization with Candida enhances risk of systemic candidiasis
in very low birth weight neonates. The J Ped 124(5):789-794,
1994
-
-
- J Scot Estep, DVM
Captain, United States Army
Registry of Veterinary Pathology*
Department of Veterinary Pathology
Armed Forces Institute of Pathology
(202) 782-2615; DSN: 662-2615
Internet: estep@afip.osd.mil
-
- * The American Veterinary Medical Association and the American
College of Veterinary Pathologists are co-sponsors of the Registry
of Veterinary Pathology. The C.L. Davis Foundation also provides
substantial support for the Registry.
-
- Return to WSC Case Menu

 4x
4x 2x
2x
 20x
20x
 40x
40x
40x
40x 40x
40x